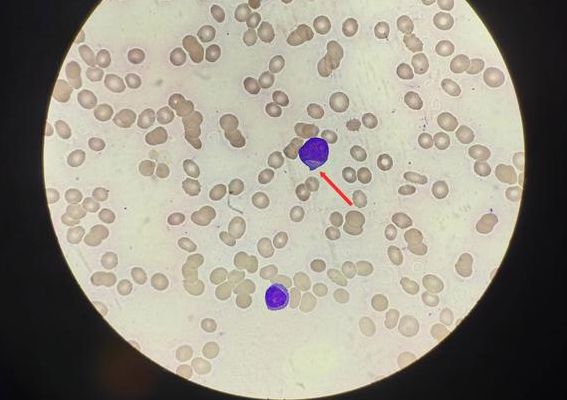

人体最小的细胞是
1、人体最大的细胞是卵细胞,最小的细胞是血小板。人体最大的细胞:卵细胞 卵细胞是人体内最大的细胞之一。在女性体内,卵细胞负责生殖功能,它是从卵巢中释放出来的。一个成熟的卵细胞直径可以达到大约20毫米或更大,这使其成为了人体内最大的细胞之一。
2、最小的是淋巴细胞。淋巴细胞是白细胞的一种,是体积最小的白细胞。其由淋巴器官产生,主要存在于淋巴管中循环的淋巴液中,是机体免疫应答功能的重要细胞成分,是淋巴系统几乎全部免疫功能的主要执行者,是对抗外界感染和监控体内细胞变异的一线“士兵”。
3、人体内最小的细胞是淋巴细胞,其直径约为6微米。人体细胞之最:- 人体最大的细胞是成熟的卵细胞,其直径约为0.1毫米。- 人体寿命最长的细胞是神经细胞。- 人体寿命最短的细胞是白细胞。皮肤细胞也需提及,作为人体最广泛的细胞类型之一。
4、人体内最大的细胞是成熟的卵细胞,其直径可达0.1毫米。 相对地,人体内最小的细胞是淋巴细胞,直径约为6微米。 在寿命方面,神经细胞是人体内寿命最长的细胞。 寿命最短的细胞则是白细胞。 结缔组织遍布人体,是分布最广的组织。
5、人体是一个充满奇迹的生命体,它拥有许多令人惊叹的“之最”。其中,最大的细胞是成熟的卵细胞,直径约为0.1毫米,而最小的细胞则是淋巴细胞,直径仅有6微米。人体的神经细胞寿命最长,而白细胞则是寿命最短的细胞。
人体最小的细胞是什么?说明理由
人体最大的细胞是卵细胞,最小的细胞是血小板。人体最大的细胞:卵细胞 卵细胞是人体内最大的细胞之一。在女性体内,卵细胞负责生殖功能,它是从卵巢中释放出来的。一个成熟的卵细胞直径可以达到大约20毫米或更大,这使其成为了人体内最大的细胞之一。
最小的是淋巴细胞。淋巴细胞是白细胞的一种,是体积最小的白细胞。其由淋巴器官产生,主要存在于淋巴管中循环的淋巴液中,是机体免疫应答功能的重要细胞成分,是淋巴系统几乎全部免疫功能的主要执行者,是对抗外界感染和监控体内细胞变异的一线“士兵”。
人体最大的细胞是卵细胞,最小的细胞是血小板。卵细胞 卵细胞是人体最大的细胞。在女性体内,卵细胞负责生殖功能,其大小随着发育阶段不断变化。初级卵母细胞是人体内最大的细胞之一,它的大小因个体差异而异,但通常比其他体细胞大得多。当卵细胞成熟并准备释放时,其直径可以达到数毫米。
最小的细胞是支原体,其相关解释如下:支原体是一种非常微小的细胞,其体积比细菌小得多,但比病毒稍大。它是目前已知的最小的细胞,也是最简单的细胞之一。支原体的体积非常小,直径只有约200纳米,因此肉眼无法看到。在显微镜下,支原体呈现出球形或圆形,有时也会呈现丝状或分支状。
人体最大的细胞是什么,最小的是什么
人体最大的细胞是卵细胞,最小的细胞是血小板。人体最大的细胞:卵细胞 卵细胞是人体内最大的细胞之一。在女性体内,卵细胞负责生殖功能,它是从卵巢中释放出来的。一个成熟的卵细胞直径可以达到大约20毫米或更大,这使其成为了人体内最大的细胞之一。
人体细胞是人体的结构和功能的基本单位。共约有40万亿—60万亿个,细胞的平均直径在10—20微米之间。除成熟的红血球和血小板外,所有细胞都有至少一个细胞核,是调节细胞生命活动、控制分裂、分化的遗传控制中心。人体细胞中最大的是成熟的卵细胞,直径在200微米左右;最小的是血小板,直径只有约2微米。
人体是一个充满奇迹的生命体,它拥有许多令人惊叹的“之最”。其中,最大的细胞是成熟的卵细胞,直径约为0.1毫米,而最小的细胞则是淋巴细胞,直径仅有6微米。人体的神经细胞寿命最长,而白细胞则是寿命最短的细胞。
人体内最大的细胞是成熟的卵细胞,其直径可达0.1毫米。 相对地,人体内最小的细胞是淋巴细胞,直径约为6微米。 在寿命方面,神经细胞是人体内寿命最长的细胞。 寿命最短的细胞则是白细胞。 结缔组织遍布人体,是分布最广的组织。
人体中最大的细胞是成熟的卵细胞,直径约为0.1毫米。相比之下,人体最小的细胞是淋巴细胞,直径仅有6微米。神经细胞是人体寿命最长的细胞,而白细胞则是寿命最短的细胞。在人体的组织分布中,结缔组织是最为广泛的。坐骨神经是人体中最长和最粗大的神经,长度约为1米,直径可达1厘米。
人体最大的细胞是成熟的卵细胞(直径0.1毫米)。 人体最小的细胞是淋巴细胞(直径6微米)。 人体寿命最长的细胞是神经细胞。 人体寿命最短的细胞是白细胞。 人体中分布最广的组织是结缔组织。 人体中最长、最粗大的神经是坐骨神经(约1米长,直径1厘米)。
文章声明:以上内容(如有图片或视频亦包括在内)除非注明,否则均为网友提供或互联网,转载或复制请以超链接形式并注明出处。